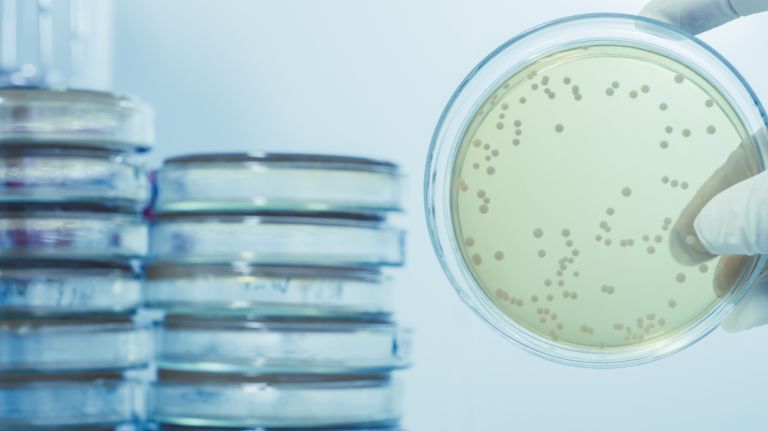
Legionnaires’ disease in Lenox Hill kills 1, sickens several others 2 A Legionnaires' disease cluster in Lenox Hill has killed one person and hospitalized six others, the city Health Department said on June 16, 2017.

The city has completed testing water from 116 cooling towers in Lenox Hill on the Upper East Side and is now awaiting the results following a deadly Legionnaires’ disease cluster that was identified last week, a Health Department spokesman said Monday.
Residents gathered Monday evening at the Lenox Hill Neighborhood House on East 70th Street to get the latest update from officials on the outbreak, which killed one person and hospitalized six others, according to health officials. No new cases have been reported since, officials said.
Rep. Carolyn Maloney, who represents the district where the cluster was found, offered her condolences to the victim’s family on Monday.
“I am deeply concerned that seven cases of Legionnaires’ disease have been reported in Lenox Hill,” Maloney said in a statement. “I offer my sincerest condolences to the family of the individual who passed away from the disease. My thoughts are with those who have been infected, and I wish them a speedy recovery.”
Maloney said her office has been in contact with the Health Department, which was “actively” sampling and testing water from cooling towers within a half kilometer radius of Lenox Hill.
Although Legionnaires’ disease cannot be passed from person to person, many cases are traced to plumbing systems that are favorable for the growth of the legionella bacteria, like cooling towers and spa tubs, hot water tanks and humidifiers, according to the health department.
Legionnaires’ disease can be especially dangerous for people older than 50, according to the Health Department. Smokers, people with chronic lung disease and those with weakened immune systems are most vulnerable.
“I urge individuals in this area with respiratory symptoms to seek medical attention right away,” Health Commissioner Dr. Mary Bassett said in a statement Friday.
Symptoms of the disease include fever, cough, muscle aches, chills, loss of appetite, fatigue, confusion and diarrhea.
In 2015, a massive and deadly Legionnaires’ disease cluster in the Bronx led to city legislation that requires building owners to take certain steps to reduce legionella growth in cooling towers, including regular cleaning and testing across the five boroughs.



































